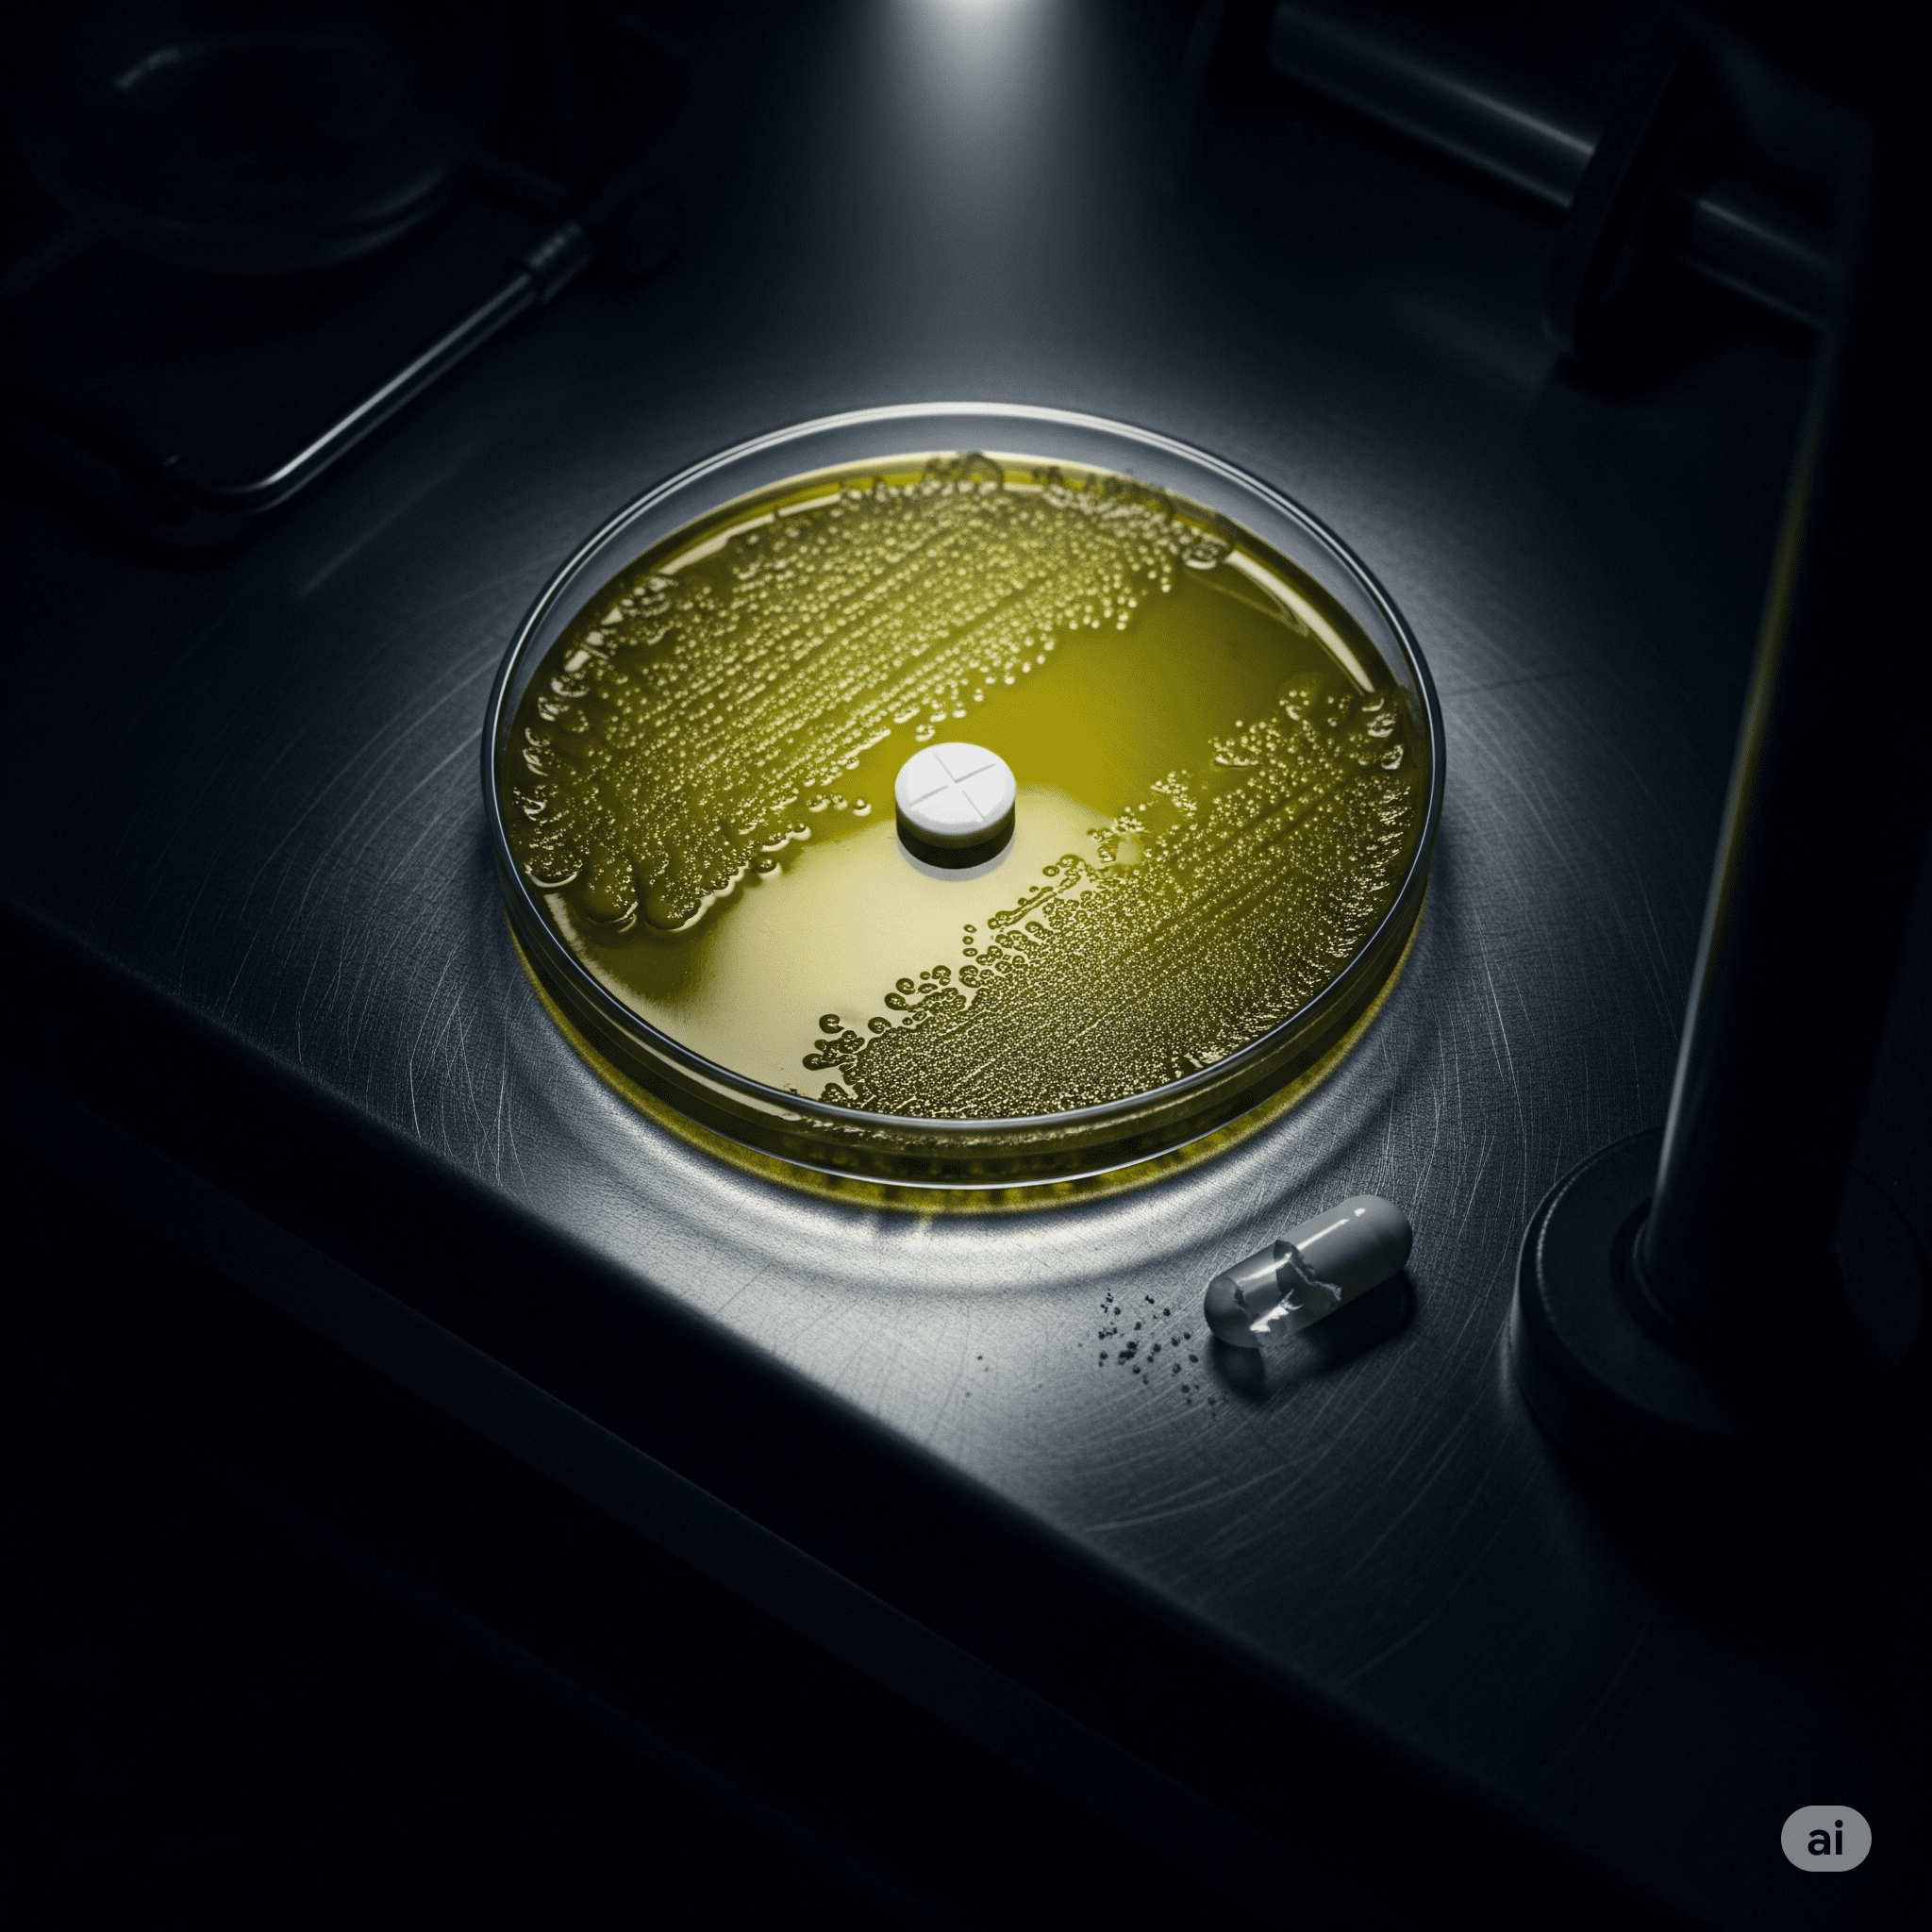

Imagine a world where a simple scraped knee could become a deadly infection and routine surgeries are too risky to perform. This isn’t science fiction. It’s the future we are rapidly approaching due to a silent pandemic known as Antimicrobial Resistance (AMR).
According to the World Health Organization (WHO), AMR is one of the top global public health threats today. In 2019 alone, drug-resistant bacteria were directly responsible for 1.27 million deaths worldwide and contributed to nearly 5 million others.
At its core, AMR happens when germs like bacteria evolve to survive the drugs designed to kill them. The main driver of this crisis is the widespread misuse and overuse of antimicrobial drugs in humans, animals, and even plants. Every time an antibiotic is used unnecessarily—for example, against a viral cold—the weakest germs are killed, but the strongest can survive, multiply, and pass on their resistance. These evolved germs are often called “superbugs”.
This dangerous evolution threatens to undo a century of medical progress. So many procedures we take for granted—from C-sections and hip replacements to cancer chemotherapy and organ transplants—rely on antibiotics to prevent infections. Without a shield of effective drugs, these life-saving treatments become a high-stakes gamble. The economic toll is also staggering; the World Bank estimates that AMR could lead to an additional US$1 trillion in healthcare costs by 2050.
Alarmingly, as old drugs fail, the pipeline for new ones is inadequate. Creating new antibiotics is incredibly expensive and not profitable for many pharmaceutical companies, leaving our medical arsenal dangerously depleted.
The fight against superbugs requires urgent global action. It involves smarter use of existing medicines, preventing infections through better sanitation and hygiene, and finding new ways to fund the creation of the next generation of cures. We are in a race against evolution, and it’s a race humanity cannot afford to lose.
Source: World Health Organization (WHO), Antimicrobial resistance Fact sheet, https://www.who.int/news-room/fact-sheets/detail/antimicrobial-resistance